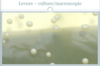

Cours 2 : Infections fongiques Flashcards
(161 cards)
Nommez les 3 types de champignons
- Levures
- Dimorphes
- Filamenteux
Nommez des exemples de levures (5)
- Candida
- Malassezia
- Trichosporon
- Cryptocoque
- Saccharomyces
Nommez des exemples de champignons dimorphes (5)
- Histoplasma
- Blastomyces
- Coccidioides
- Paracoccidioides
- Penicillium
Nommez des exemples de champignons filamenteux (3)
- Dermatophytes
- Mucorales
- Hyalo- et phaeo- hyphomycètes
Décrire : Levure (4)
- Organismes unicellulaires
- Structures rondes à ovales
- Multiplication via bourgeonnement
- Macroscopie : colonies rondes, convexes, glabres
Décrire : Dermatophyte (4)
- Organismes pluricellulaires
- Structures filamenteuses
- Propagation via conidies/spores
- Macroscopie : colonies «poilues» (filament aérien) à poudreuses

Les mycoses cutanées SUPERFICIELLES atteignent quoi? (3)
Atteint couche cornée, cheveux et ongles
Les mycoses cutanées SOUS-CUTANÉES atteignent quoi? (2)
- Atteint derme ou tissu sous- cutané,
- souvent du à inoculation directe
Décrire : Mycoses cutanées SYSTÉMIQUE «PROFONDES»
- 1) Pathogènes «vrais» et 2) Opportunistes
- Atteint derme et tissu sous- cutané, souvent 2° dissémination hématogène ou extension à partir structures sous-jacentes
- Lésions cutanées 1° ou 2° chez les immunosupprimés
Nommez : Mycoses superficielles fréquentes de la peau avec pathogène associé

Décrire : Pityriasis versicolore (2)
- Mycose superficielle très fréquente, surtout les régions avec t° et humidité élevées
- Fréquent chez adolescents et jeunes adultes
Pityriasis versicolore est causé par quoi? (2)
Malassezia globosa > M. furfur
Décrire présentation : Pityriasis versicolore (6)
- Macules rosées, rouges ou brunes squameuses ovales, avec aspect papier parchemin caractéristique
- Tronc/membres supérieurs, avec lésions souvent coalescentes au centre
- Prurit léger ou absent
- Zones atteintes ne bronzent pas au soleil : lésions apparaissent souvent pâles l’été (p/r peau bronzée qui les entourent) et foncées l’hiver
- Hypopigmentation post-inflammatoire fréquente
- Forme inversée existe
La Pityriasis versicolore ressemble à quoi à la lampe de Wood? (1)
Lampe de Wood : fluorescence jaune-orange
Identifiez

Tinéa versicolore
Identifiez

Tinéa versicolore
Identifiez

Pityriasis versicolore – aspect plissé caractéristique
Identifiez

Pityriasis versicolore – variante hypopigmentée
Identifiez

Pityriasis versicolore hypopigmenté en gouttes
Nommez les types de dermatophytes (3)
- Anthropophilique
- Zoophilique
- Géophilique
C’est quoi le mode de transmission pour les dermatophytes :
- Anthropophilique
- Zoophilique
- Géophilique
- Anthropophilique : Humain à humain
- Zoophilique : Animal à humain
- Géophilique : Terre à humain/animal
Nommez les caractéristiques cliniques typiques : Dermatophytes Anthropophilique (2)
- Peu ou pas inflammatoire
- Chronique
Nommez les caractéristiques cliniques typiques : Dermatophytes Zoophilique (2)
- Inflammation intense (pustules et vésicules possibles)
- Aigue
Nommez les caractéristiques cliniques typiques : Dermatophytes Géophilique (1)
Inflammation modérée








































